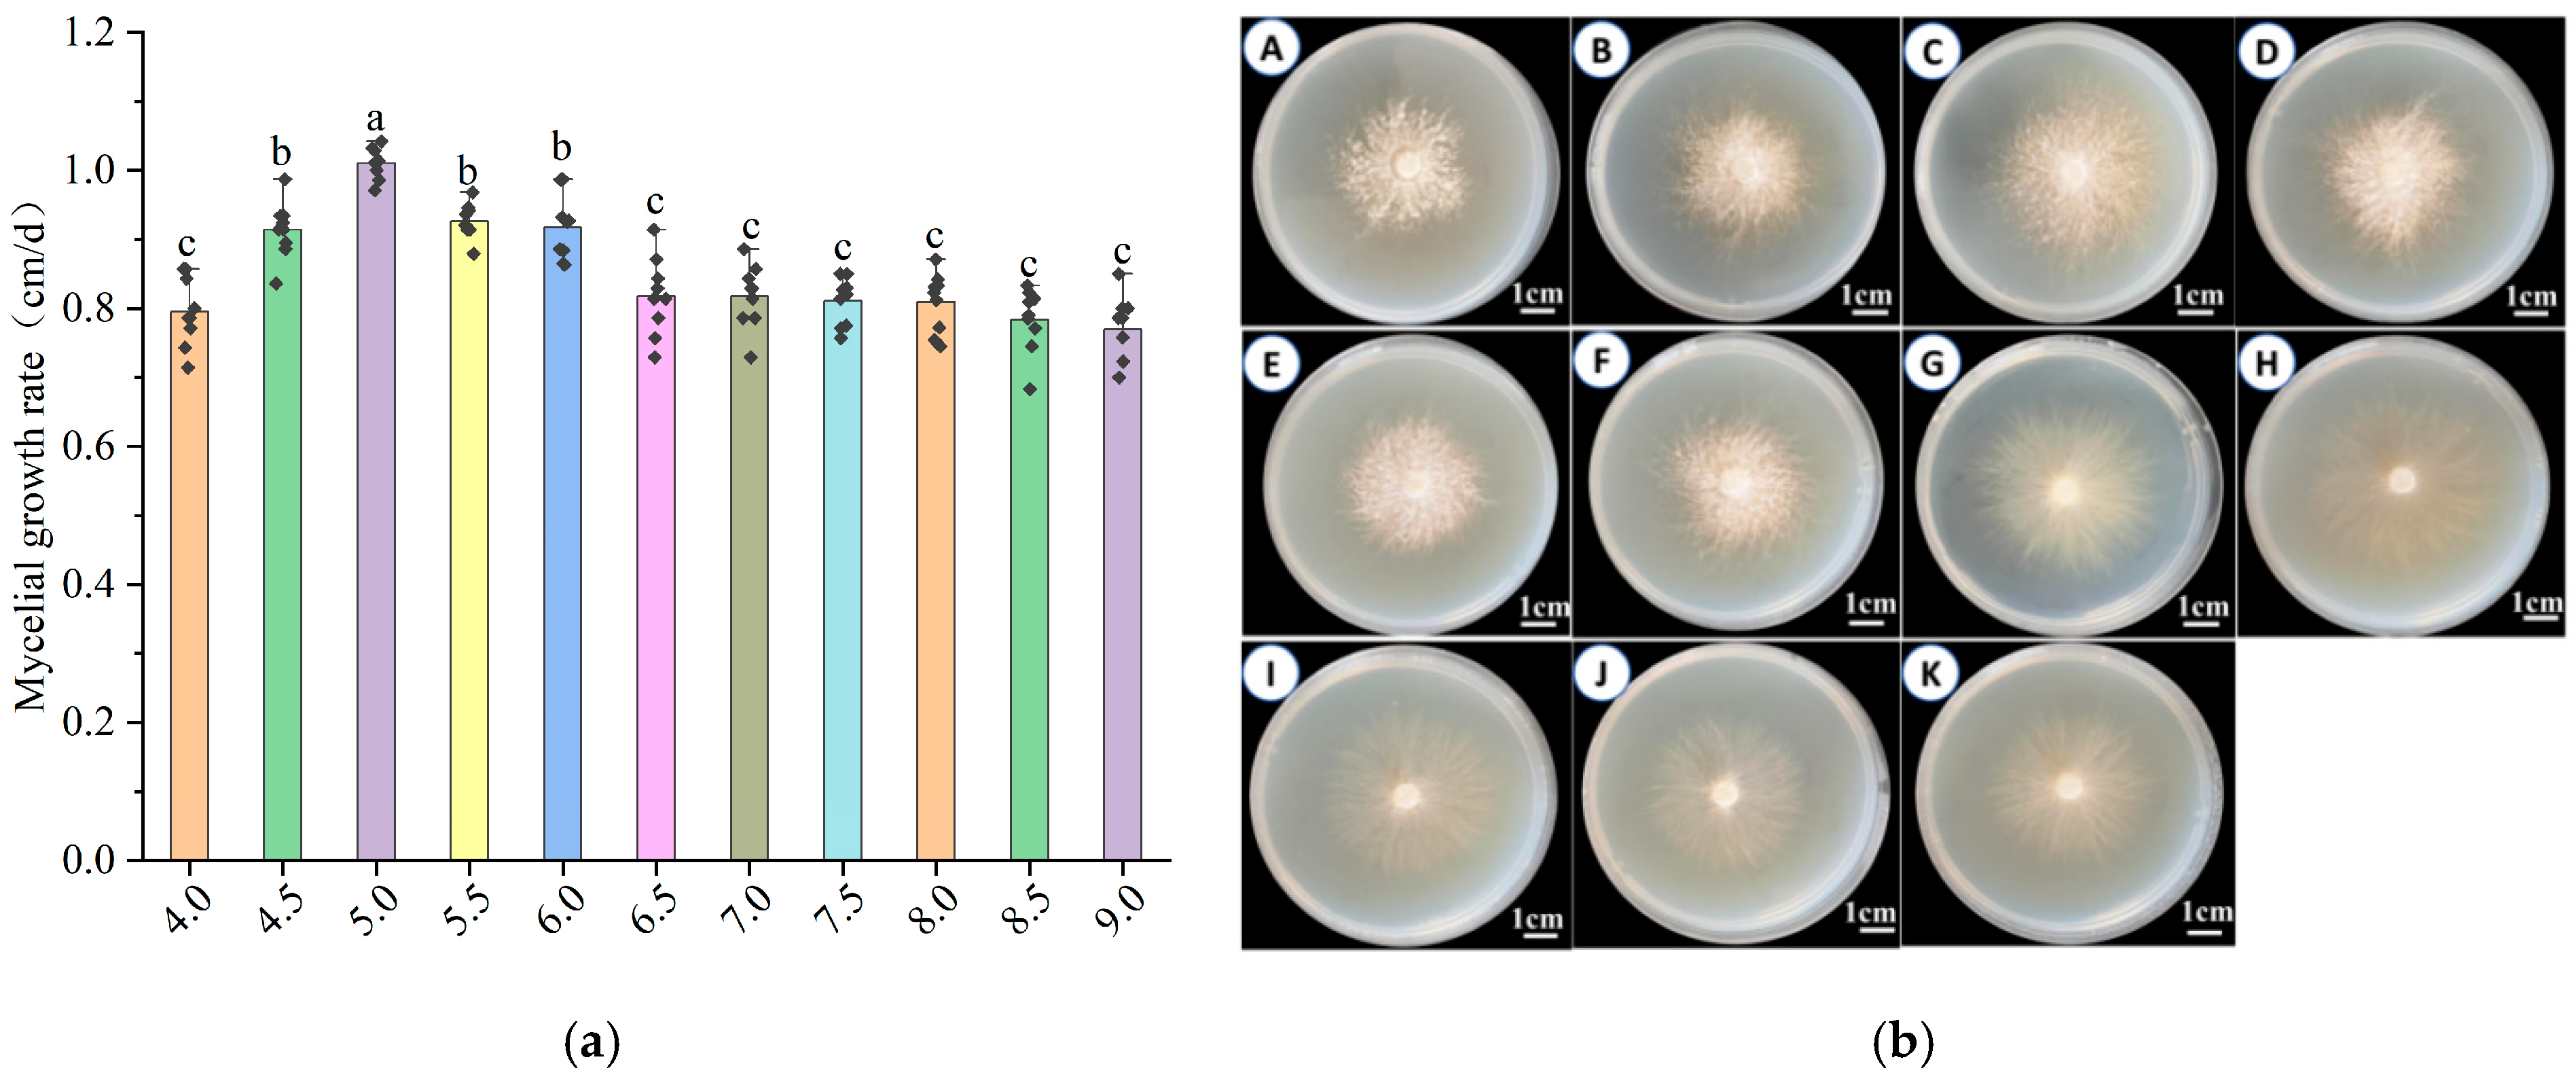
Horticulturae 11 00917 g005 Horticulturae 11 00917 g005
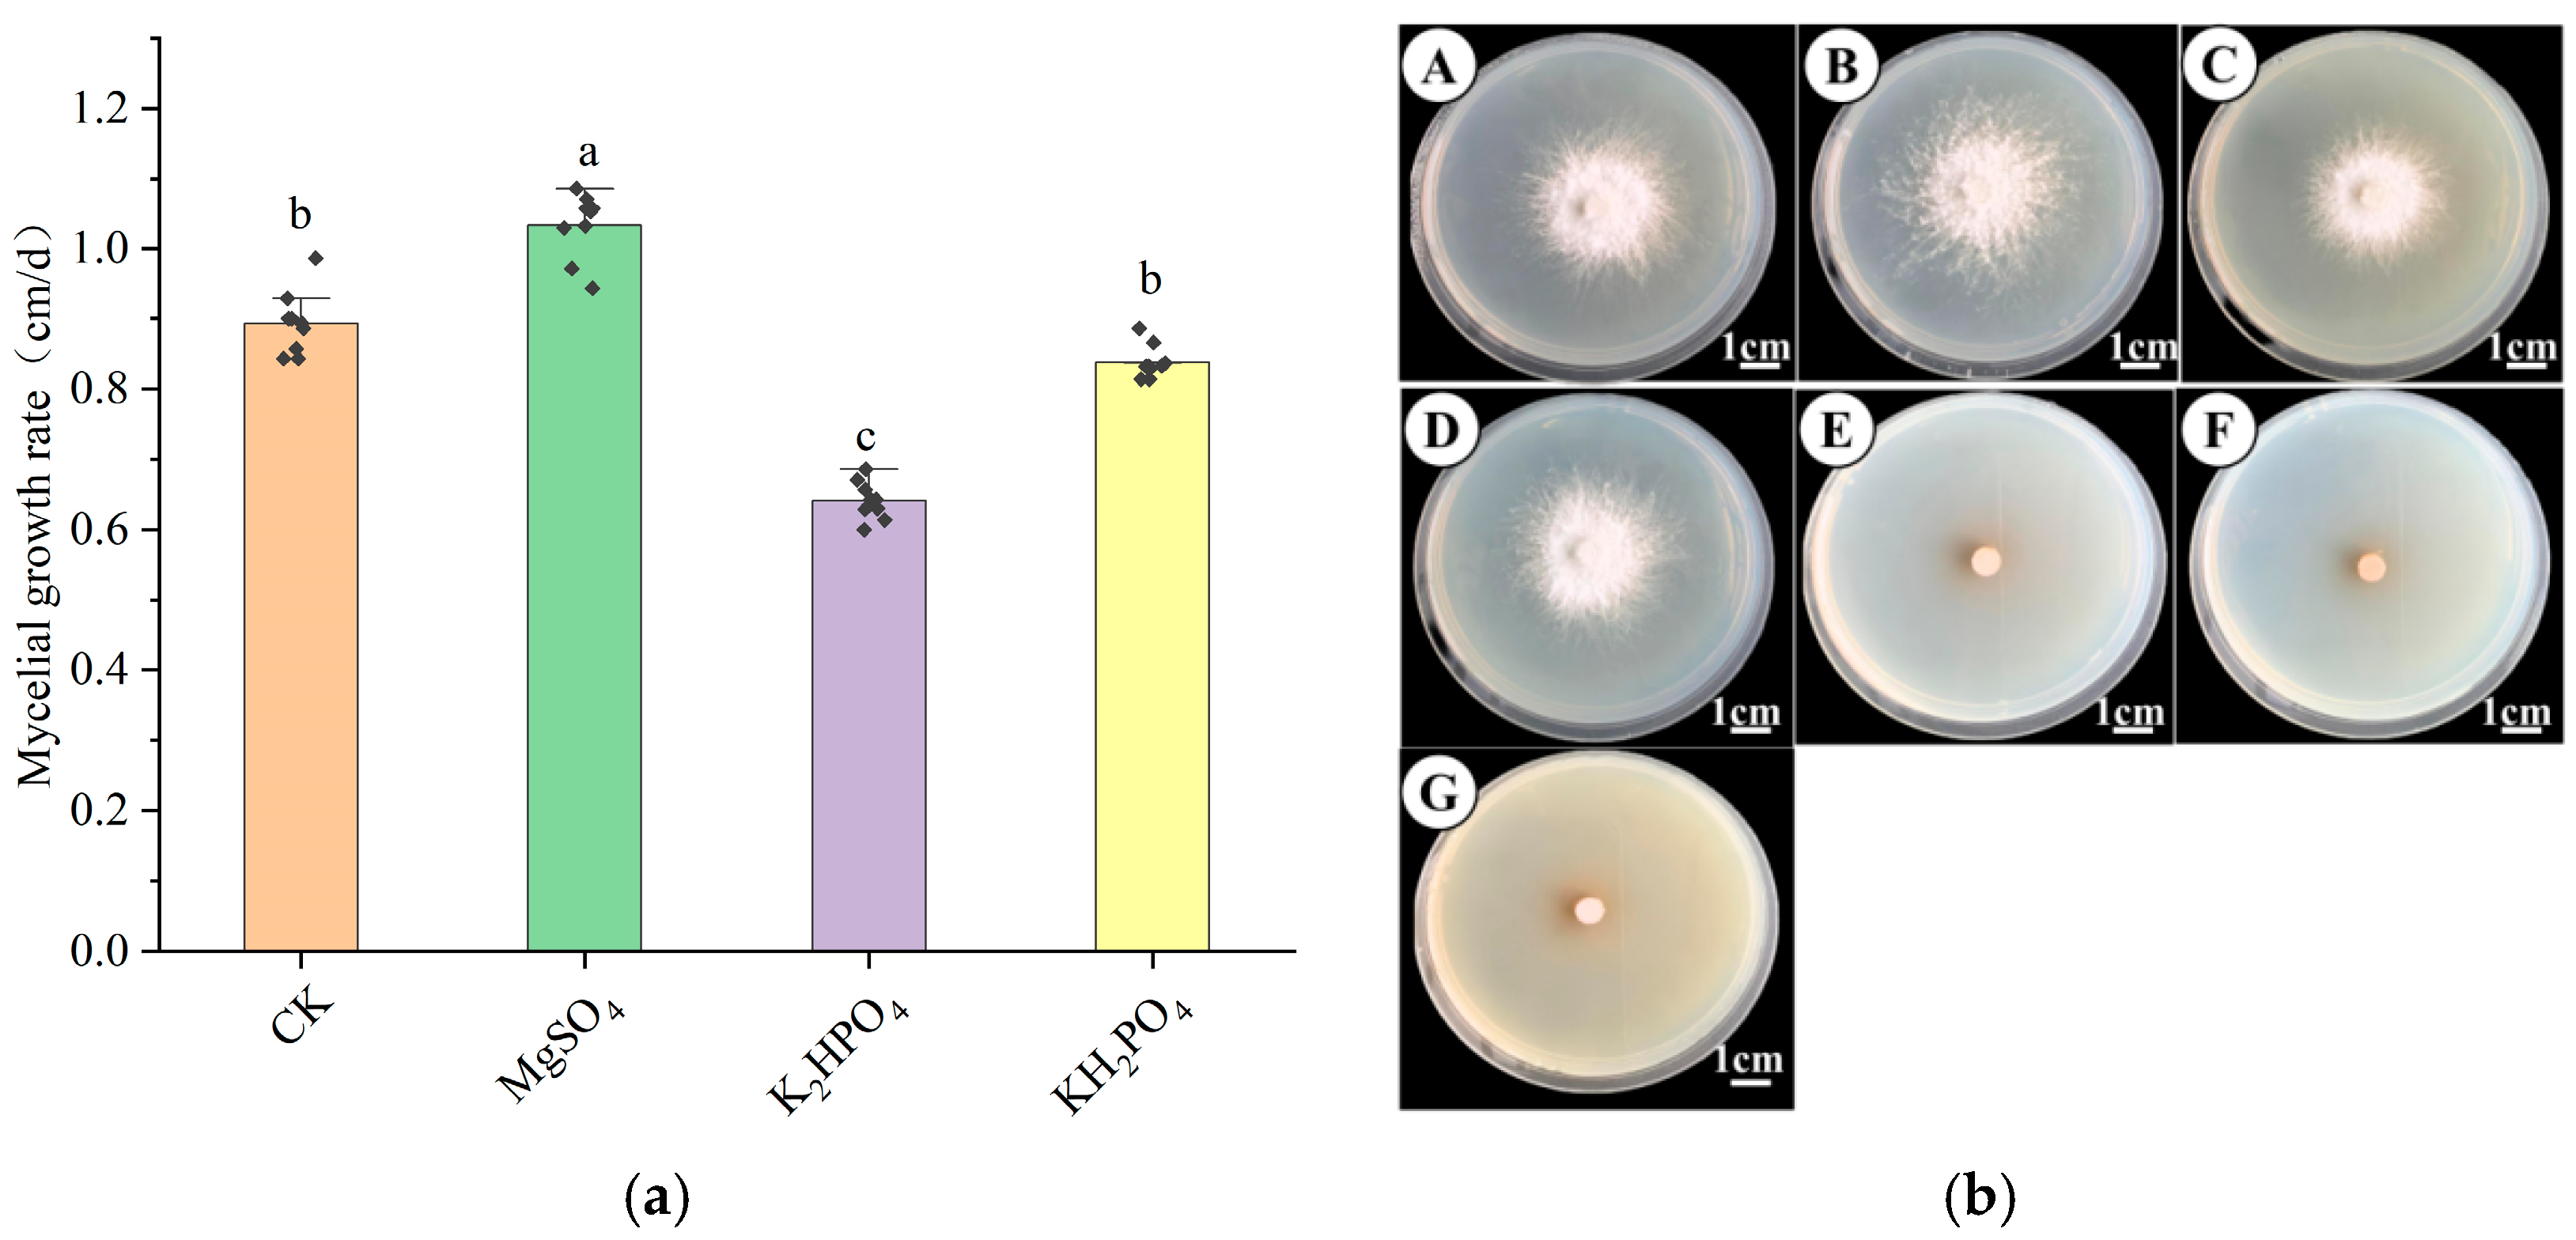
Horticulturae 11 00917 g006 Horticulturae 11 00917 g006
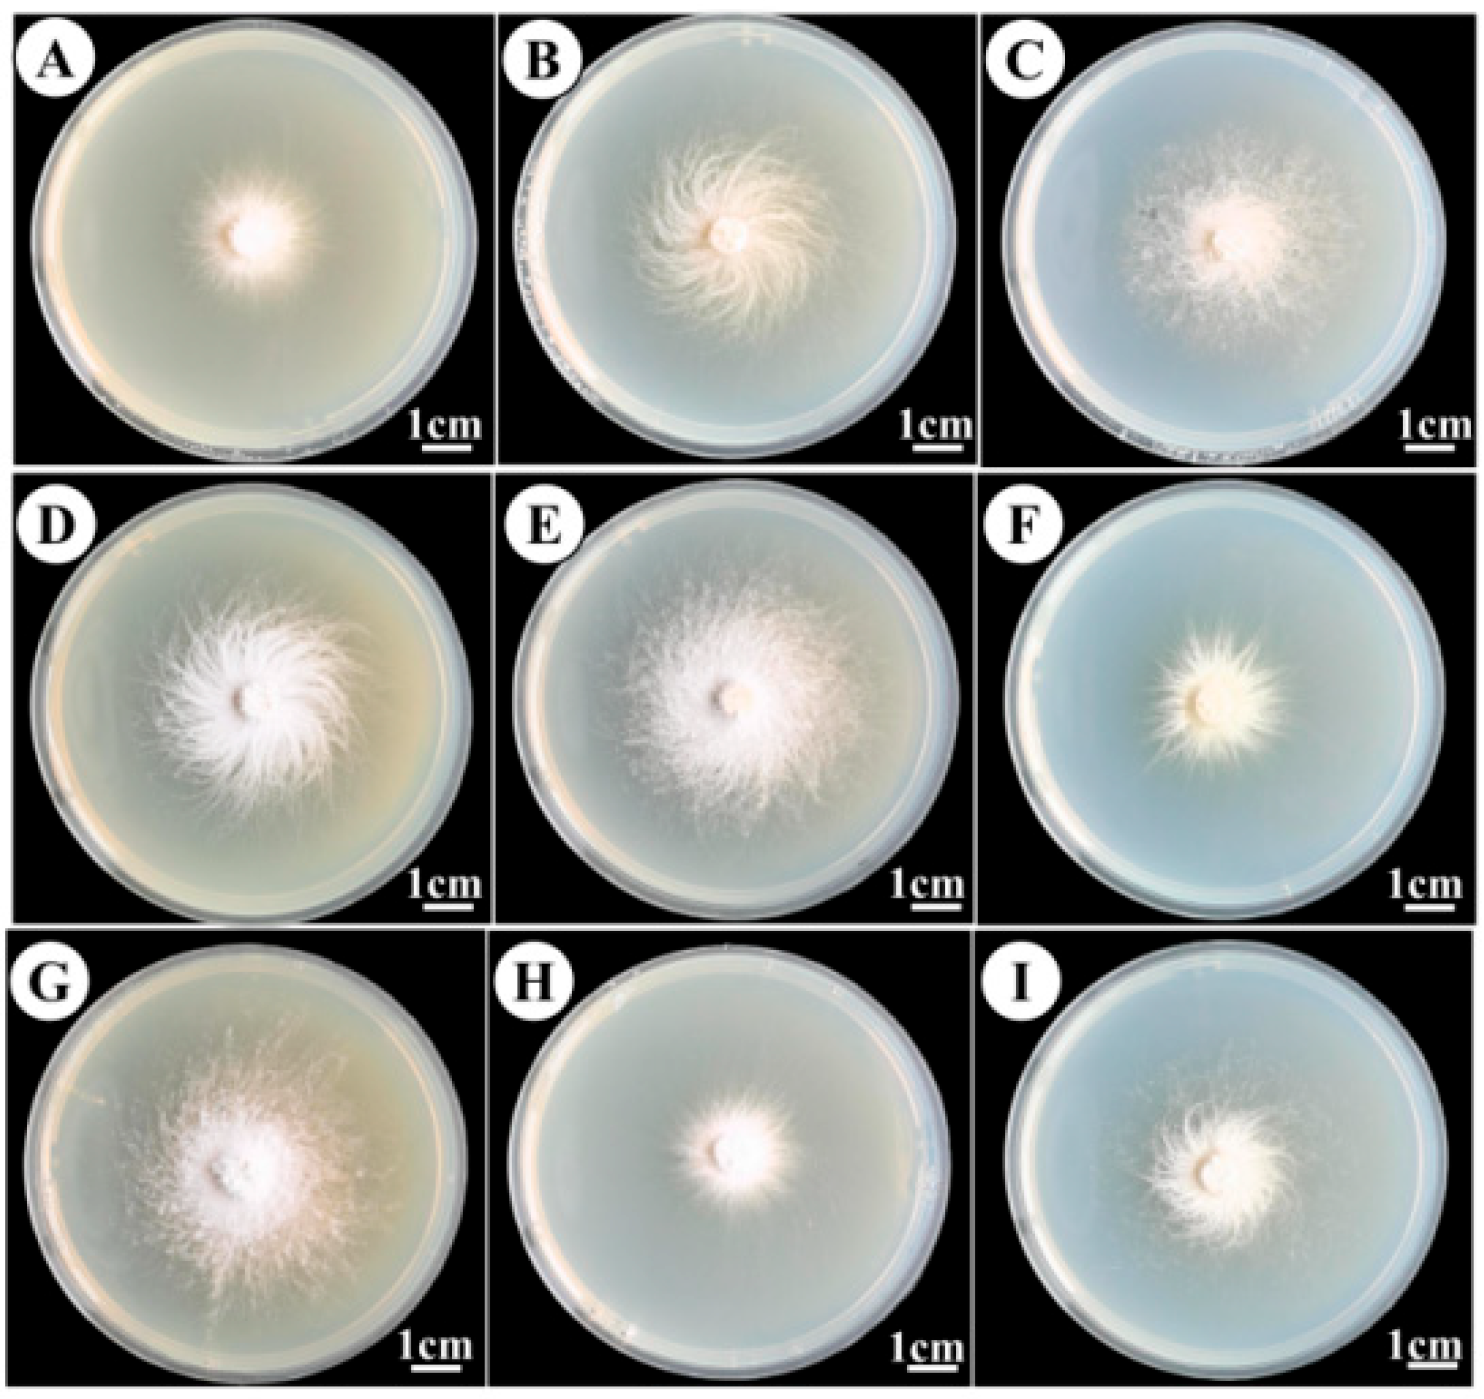
Horticulturae 11 00917 g007 Horticulturae 11 00917 g007

Biological Characteristics and Domestication of a Wild Hericium coralloides
Abstract
1. Introduction
2. Materials and Methods
2.1. Test Strains
2.2. The Composition of the Medium
2.3. Separation and Culture
2.4. Morphological Identification Method
2.5. Molecular Identification
2.6. Biological Characteristics Test
2.6.1. Carbon Source Test
2.6.2. Nitrogen Source Test
2.6.3. pH Experiment
2.6.4. Temperature Experiment
2.6.5. Inorganic Salt Experiment
2.6.6. Orthogonal Test
2.7. Cultivation Experiment
2.8. Composition Analysis of the Fruiting Body
2.9. Data Processing
3. Results
3.1. Morphological Identification
3.2. Molecular Biological Identification
3.3. Biological Characteristics
3.3.1. Effects of Different Carbon Sources on the Mycelial Growth of H. coralloides
3.3.2. Effects of Different Nitrogen Sources on the Mycelial Growth of H. coralloides
3.3.3. Effects of Different Temperatures on the Mycelial Growth of H. coralloides
3.3.4. Effects of Different pH on the Mycelial Growth of H. coralloides
3.3.5. Effects of Different Inorganic Salts on the Mycelial Growth of H. coralloides
3.4. Orthogonal Test Results
3.5. Domestication Cultivation
3.6. Component Determination
4. Discussion
5. Conclusions
Author Contributions
Funding
Data Availability Statement
Conflicts of Interest
References
- Wang, F.; Wang, K.; Cai, L.; Zhao, M.; Kirk, P.M.; Fan, G.; Sun, Q.; Li, B.; Wang, S.; Yu, Z.; et al. Fungal names: A comprehensive nomenclatural repository and knowledge base for fungal taxonomy. Nucleic Acids Res. 2023, 51, D708–D716. [Google Scholar] [CrossRef]
- Zhuang, L.; Sun, Z.H.; Yu, S.T.; Guo, X.X.; Yang, N. New cultivar‘ZLsh-1’of Hericium coralloides. Mycosystema 2024, 43, 155–162. [Google Scholar] [CrossRef]
- Tu, X.Y.; Chu, L.L.; Wang, M.; Chen, B.Z.; Jiang, Y.J. Extraction of polysacchsride from hericium corallinum and analysis on its in vitro antioxidant activity. Biotechnol. Bull. 2023, 39, 276–286. [Google Scholar] [CrossRef]
- Yu, J.Q.; Wu, K.Y.; Chen, Z.R.; Wang, J.H.; Zhang, X.; Wang, C.Y. Study on the optimization of ultrasonicassisted extraction process of Hercium coralloides(Scop.) Pers. Polysaccharides and its anti-colorectal cancer activity. Biotechnol. Bull. 2024, 40, 78–87. [Google Scholar] [CrossRef]
- Zhang, J.; Zhang, J.; Zhao, L.; Shui, X.; Wang, L.A.; Wu, Y. Antioxidant and Anti-Aging Activities of Ethyl Acetate Extract of the Coral Tooth Mushroom, Hericium coralloides (Agaricomycetes). Int. J. Med. Mushrooms 2019, 21, 561–570. [Google Scholar] [CrossRef]
- Vedenicheva, N.P.; Al-Maali, G.A.; Bisko, N.A.; Kosakivska, I.V.; Ostrovska, G.V.; Khranovska, N.M.; Gorbach, O.I.; Garmanchuk, L.V.; Ostapchenko, L.I. Effect of Cytokinin-Containing Extracts from Some Medicinal Mushroom Mycelia on HepG2 Cells In Vitro. Int. J. Med. Mushrooms 2021, 23, 15–28. [Google Scholar] [CrossRef]
- Williams, L.M.; Berthon, B.S.; Stoodley, I.L.; Williams, E.J.; Wood, L.G. Medicinal Mushroom Extracts from Hericium coralloides and Trametes versicolor Exert Differential Immunomodulatory Effects on Immune Cells from Older Adults In Vitro. Nutrients 2023, 15, 2227. [Google Scholar] [CrossRef]
- Meng, J.L.; Tian, M.; Feng, C.P.; Chang, M.C.; Cheng, H.Y. Components of Hericium coralloids and Effects of Polysaccharide on Immune and Antioxidant Function in Mice. J. Chin. Inst. Food Sci. Technol. 2016, 16, 50–55. [Google Scholar] [CrossRef]
- Tabibzadeh, F.; Alvandi, H.; Hatamian-Zarmi, A.; Kalitukha, L.; Aghajani, H.; Ebrahimi-Hosseinzadeh, B. Antioxidant activity and cytotoxicity of exopolysaccharide from mushroom Hericium coralloides in submerged fermentation. Biomass Convers. Biorefin 2022, 14, 26953–26963. [Google Scholar] [CrossRef]
- Liu, J.Y.; Hou, X.X.; Li, Z.Y.; Shan, S.H.; Chang, M.C.; Feng, C.P.; Wei, Y. Isolation and structural characterization of a novel polysaccharide from Hericium erinaceus fruiting bodies and its arrest of cell cycle at S-phage in colon cancer cells. Int. J. Biol. Macromol. 2020, 157, 288–295. [Google Scholar] [CrossRef]
- Hou, X.X.; Liu, J.Y.; Li, Z.Y.; Chang, M.C.; Guo, M.; Feng, C.P.; Shi, J.Y. Fruiting body polysaccharides of Hericium erinaceus induce apoptosis in human colorectal cancer cells via ROS generation mediating caspase-9-dependent signaling pathways. Food Funct. 2020, 11, 6128–6138. [Google Scholar] [CrossRef]
- Cheng, Y.F.; Han, A.L.; Yun, S.J.; Chang, M.C.; Meng, J.L.; Feng, C.R. Cholesterol-lowering effect of H.coralloides polysaccharides and ITS mechanism. Acta Nutr. Sin. 2018, 40, 172–176. [Google Scholar] [CrossRef]
- Zhang, W.T.; Yao, F.J.; Fang, M.; Zhang, Y.M.; Ma, X.X.; Huang, C.Y.; Zhang, Y. Study on liquid culture of Hericium Coralloides and its cultivation effects. J. Northeast. Agric. Sci. 2021, 46, 125–131. [Google Scholar] [CrossRef]
- Qu, N.; Liu, D.; Wang, H.; Wang, J.W.; Liu, Y.B.; Xu, T.J.; Hu, X. Study on the Optimal medium formula of wild coral Hericium coralloides(Scop.)Pers.in Changbai Motntain. Edible Fungi China 2020, 39, 17–19. [Google Scholar] [CrossRef]
- Fan, Y.G.; Bau, T. Cultivation techniques of wild edible mushroom Hericium coralloides (Scop.) Pers. collected from Changbaishan Nature reserve. Edible Fungi China 2010, 29, 10–11. [Google Scholar] [CrossRef]
- Chen, S.; Liu, S.J.; Gao, Y.; Song, Z.K.; Ma, H.X. Biological characteristics and domestic cultivation of wild Ganoderma gibbosum. Mycosystema 2023, 42, 2218–2230. [Google Scholar] [CrossRef]
- Ge, Y.H.; He, J.Q.; Han, Z.; Xu, D.; Liu, H.X. Biological characteristics and domestication cultivation of Sparassis subalpina. Mycosystema 2024, 43, 156–173. [Google Scholar] [CrossRef]
- Li, M.L.; Zhu, A.H.; Ma, G.Y.; Qu, Z.; Lu, X.H.; Ma, H.X.; Liu, Z.D. Biological characteristics and domestication of wild Pleurotus giganteus. Mycosystema 2025, 44, 65–78. [Google Scholar] [CrossRef]
- GB/T 5009.10-2003; Determination of Crude Fiber in Vegetable Foods. Standardization Administration of China: Beijing, China, 2003.
- GB 5009.5-2016; National Food Safety Standard—Determination of Protein in Foods. National Health and Family Planning Commission of the People’s Republic of China: Beijing, China, 2016.
- GB 5009.6-2016; National Food Safety Standard—Determination of Fat Content in Foods. National Health and Family Planning Commission of the People’s Republic of China: Beijing, China, 2016.
- GB 5009.3-2016; National Food Safety Standard—Determination of Moisture Content in Foods. National Health and Family Planning Commission of the People’s Republic of China: Beijing, China, 2016.
- GB 5009.124-2016; National Food Safety Standard—Determination of Amino Acids in Foods. National Health and Family Planning Commission of the People’s Republic of China: Beijing, China, 2016.
- Chen, J.L.; Yang, Y.K.; Wu, G.F.; Liu, P.; Li, Y. Biological characteristics and domestic cultivation of a wild Bondarzewia dickinsii strain. Mycosystema 2025, 44, 33–43. [Google Scholar] [CrossRef]
- Zhai, L.N.; Tang, Q.J.; Zhou, B.J.; Zhou, S.Z.; Wang, H.J.; Yun, Y.; Han, Y.S.; Wang, Q.Y.; Yan, X.W.; Xing, F.N. Genetic diversity analysis and core germplasm construction of oryza rufipogon Griff.in Hainan. J. Plant Genet. Resour. 2024, 25, 1624–1636. [Google Scholar] [CrossRef]
- Wang, S.Y.; Zhang, J.L. Biological characterization and domestication of a wild Panus conchatus strain. Mycosystema 2024, 43, 148–155. [Google Scholar] [CrossRef]
- Tian, R.; Chrn, L.F.; Zhao, R.X.; Zeng, N.K. Biological characteristics and cultivation of Ganoderma subflexipes. Mycosystema 2024, 43, 48–65. [Google Scholar] [CrossRef]
- Liang, Q.Q.; Ding, L.Q.; Tian, L.W.; Wang, Y.Z.; Niu, X.; Dan, H.J. Domestication and cultivation of a wild brown strain of Agaricus bisporus collected from Qilian Mountains. Mycosystema 2025, 44, 119–131. [Google Scholar] [CrossRef]
- Gao, Z.Y.; Han, H.L.; Feng, L.N.; Cheng, X.Y.; Zhang, J.Z.; Wang, X.H.; Sun, W.M. Domestic cultivation of Trametes sanguinea. Mycosystema 2024, 43, 174–188. [Google Scholar] [CrossRef]
- Li, M.M.; Lin, J.T.; Huang, Z.X.; Liang, Y.L.; Huang, F.C.; Liu, B. Biological characteristics and domestication cultivation of Trametes elegans. Mycosystema 2023, 42, 1506–1516. [Google Scholar] [CrossRef]
- Song, J.L.; Wang, W.K.; Cheng, J.W.; Lu, N.; Yan, J.; Kang, X.P.; Yuan, W.D. Isolation and cultivation of wild Sanghuangporue. J. Northwest A F Univ. 2020, 48, 129–136. [Google Scholar] [CrossRef]
- An, Q.; Wu, X.J.; Wu, B.; Dai, Y.C. Effects of carbon and nitrogen sources on lignocellulose decomposition enzyme activities in Flammulina velutipes. Mycosystema 2015, 34, 761–771. [Google Scholar] [CrossRef]
- Tatsuno, K.; Yamada-Okabe, H.; Takagi, M.; Arisawa, M.; Sudoh, M. Properties of yeast expressed Aspergillus nidulans chitin synthase B which is essential for hyphal growth. FEMS Microbiol. Lett. 1997, 149, 279–284. [Google Scholar] [CrossRef]
- Lu, M.Z.; Wang, S.W.; Xu, J.Z. Wild Polyporus alveolaris Separate Isolation and Identification of Biological Characteristics. J. Northeast. For. Univ. 2016, 44, 76–79. [Google Scholar] [CrossRef]
- Chu, X.Z.; Liu, X.; Gong, P.; Liu, G.; Wang, B.R.; Gao, X. Effects of different matrix on growth, decelopment, nutrient and mineral element content of Pleurotus ostreatus. China Cucurbits Veg. 2024, 37, 90–95. [Google Scholar] [CrossRef]
- Li, B.; Cen, G.H.; Qiu, Y.; Chen, B.Z.; Deng, Y.J.; Xie, B.G.; Liu, F. Breeding of Flammylina filiformis‘Nongwanjin 8’,F.filiformis‘Nongwanjin 9’and Hypsizygus marmireus‘Nongwanzhen 1’. Mycosystema 2024, 43, 259–265. [Google Scholar] [CrossRef]
- Kim, M.-Y.; Chung, l.-M.; Lee, S.-J.; Ahn, J.-K.; Kim, E.-H.; Kim, M.-J.; Kim, S.-L.; Moon, H.-I.; Ro, H.-M.; Kang, E.-Y.; et al. Comparison of free amino acid, carbohydrates concentrations in Korean edible and medicinal mushrooms. Food Chem. 2009, 113, 386–393. [Google Scholar] [CrossRef]
- Yin, M.; Chen, M.; Yanagisawa, T.; Matsuoka, R.; Xi, Y.; Tao, N.; Wang, X. Physical properties, chemical composition, and nutritional evaluation of common salad dressings. Front. Nutr. 2022, 9, 978648. [Google Scholar] [CrossRef] [PubMed]
- Qu, M.Q.; Yang, S.S.; Yu, C.X.; Li, H.H.; Lin, Q.Y.; Chen, M.J.; Li, C.H. Nutritional Evaluttion of wiil and corresponding cultivated Hericium erinaceus. Acta Edulis Fungi 2020, 27, 131–142. [Google Scholar] [CrossRef]
- Huang, W.H.; Chen, H.Y.; Bao, D.P.; Yang, R.H.; Tao, X.S.; Wu, G.F.; Huang, J.F. Agronomic traits of wild Lentinus edodes strains and amino acid nutritional profile of the fruit bodies. Shanghai Agric. Sci. 2023, 39, 32–39. [Google Scholar] [CrossRef]
- Lin, F.; Gao, Y.Y.; Zhao, Y.; Yan, S.Y.; Chen, M.J. Comparison of biological characteristics of different Volvariella volvacea strains. Guangdong Agric. Sci. 2014, 41, 29–32. [Google Scholar] [CrossRef]
- Sun, Y.; Li, L.; Liu, N.; Wang, Y.Z.; Pan, G.C.; Zou, F.L.; Yang, X.; Long, H.W. Study on Breeding Varieties of Dictyophora rubrovolvata. Edible Fungi China 2020, 39, 12–15. [Google Scholar] [CrossRef]
- Xiao, Z.T.; He, H.Q.; Peng, Y.Y.; Liu, M.; Xu, J. Identification and Domestication of a Wild Pleurotus cystidiosus. Spec. Wild Econ. Anim. Plant Res. 2023, 45, 108–115. [Google Scholar] [CrossRef]

| Level | Factor | |||
|---|---|---|---|---|
| Carbon Source | Nitrogen Source | Temperature (°C) | pH | |
| Level 1 | Maltose | Yeast extract | 20 | 5.0 |
| Level 2 | Mannose | Peptone | 25 | 5.5 |
| Level 3 | Glucose | (NH4)2SO4 | 30 | 6.0 |
| Serial Number | Carbon Source | Nitrogen Source | Temperature (°C) | pH | Average Mycelium Growth Rate (cm/d) | Mycelium Growth |
|---|---|---|---|---|---|---|
| A | 1 (Maltose) | 1 (Yeast extract) | 1 (20) | 1 (5.0) | 0.711 ± 0.065 f | ++++ |
| B | 1 (Maltose) | 2 (Peptone) | 2 (25) | 2 (5.5) | 1.014 ± 0.027 bc | ++++ |
| C | 1 (Maltose) | 3 ((NH4)2SO4) | 3 (30) | 3 (6.0) | 1.036 ± 0.041 b | ++++ |
| D | 2 (Mannose) | 1 (Yeast extract) | 2 (25) | 3 (6.0) | 1.014 ± 0.056 bc | ++++ |
| E | 2 (Mannose) | 2 (Peptone) | 3 (30) | 1 (5.0) | 1.149 ± 0.040 a | ++++ |
| F | 2 (Mannose) | 3 ((NH4)2SO4) | 1 (20) | 2 (5.5) | 0.860 ± 0.042 d | ++++ |
| G | 3 (Glucose) | 1 (Yeast extract) | 3 (30) | 2 (5.5) | 1.128 ± 0.042 a | ++++ |
| H | 3 (Glucose) | 2 (Peptone) | 1 (20) | 3 (6.0) | 0.811 ± 0.046 e | ++++ |
| I | 3 (Glucose) | 3 ((NH4)2SO4) | 2 (25) | 1 (5.0) | 0.992 ± 0.038 c | ++++ |
| T1 | 2.761 | 2.853 | 2.382 | 2.852 | ||
| T2 | 3.023 | 2.974 | 3.02 | 3.002 | ||
| T3 | 2.931 | 2.888 | 3.313 | 2.861 | ||
| K1 | 0.920 | 0.951 | 0.794 | 0.951 | ||
| K2 | 1.008 | 0.991 | 1.007 | 1.001 | ||
| K3 | 0.977 | 0.963 | 1.104 | 0.954 | ||
| R | 0.262 | 0.121 | 0.931 | 0.150 | ||
| Optimum level | A2 | B2 | C3 | D2 | ||
| Optimal composition | A2B2C3D2 | |||||
| Source | Sum of Squares | Degree of Freedom (df) | Mean Square | F | p | Significance |
|---|---|---|---|---|---|---|
| Carbon source | 0.0099 | 2 | 0.00495 | 33 | 0.001 | p < 0.01 |
| Nitrogen source | 0.0025 | 2 | 0.00125 | 8.33 | 0.015 | p < 0.05 |
| Temperature | 0.1524 | 2 | 0.0762 | 508 | 0.000 | p < 0.01 |
| pH | 0.0003 | 2 | 0.00015 | 2 | 0.22 | p > 0.05 |
| Error | 0.0003 | 2 | 0.00015 |
| Main Ingredients | Ingredient Content (g/100 g) | |
|---|---|---|
| Essential amino acid | Ala | 0.150 |
| Lys | 0.098 | |
| Leu | 0.150 | |
| Lie | 0.080 | |
| Pro | 0.100 | |
| Phe | 0.080 | |
| Met | 0.020 | |
| Thr | 0.083 | |
| Val | 0.095 | |
| Gly | 0.082 | |
| Non-essential | Arg | 0.091 |
| Asp | 0.170 | |
| Glu | 0.380 | |
| His | 0.057 | |
| Ser | 0.093 | |
| Tyr | 0.031 | |
| Total essential amino acid (EAA, g/100 g) | 0.938 | |
| Total non-essential amino acid (NEAA, g/100 g) | 0.822 | |
| Total content of amino acids (TAA, g/100 g) | 1.760 | |
| Umami amino acids (UAA, g/100 g) | 0.550 | |
| Sweet amino acid (SAA, g/100 g) | 0.408 | |
| EAA/NEAA (%) | 114.110 | |
| EAA/TAA (%) | 53.300 | |
| Protein (g/100 g) | 2.430 | |
| Coarse fiber (%) | 0.800 | |
| Fat (g/100 g) | 0.500 | |
| Water (g/100 g) | 87.800 | |
Disclaimer/Publisher’s Note: The statements, opinions and data contained in all publications are solely those of the individual author(s) and contributor(s) and not of MDPI and/or the editor(s). MDPI and/or the editor(s) disclaim responsibility for any injury to people or property resulting from any ideas, methods, instructions or products referred to in the content. |
© 2025 by the authors. Licensee MDPI, Basel, Switzerland. This article is an open access article distributed under the terms and conditions of the Creative Commons Attribution (CC BY) license (https://creativecommons.org/licenses/by/4.0/).
Share and Cite
Song, J.-L.; Xin, Y.; Zhou, Z.-F.; Kang, X.-P.; Zhang, Y.; Yuan, W.-D.; Yu, B. Biological Characteristics and Domestication of a Wild Hericium coralloides. Horticulturae 2025, 11, 917. https://doi.org/10.3390/horticulturae11080917
Song J-L, Xin Y, Zhou Z-F, Kang X-P, Zhang Y, Yuan W-D, Yu B. Biological Characteristics and Domestication of a Wild Hericium coralloides. Horticulturae. 2025; 11(8):917. https://doi.org/10.3390/horticulturae11080917
Chicago/Turabian StyleSong, Ji-Ling, Ya Xin, Zu-Fa Zhou, Xue-Ping Kang, Yang Zhang, Wei-Dong Yuan, and Bin Yu. 2025. "Biological Characteristics and Domestication of a Wild Hericium coralloides" Horticulturae 11, no. 8: 917. https://doi.org/10.3390/horticulturae11080917
APA StyleSong, J.-L., Xin, Y., Zhou, Z.-F., Kang, X.-P., Zhang, Y., Yuan, W.-D., & Yu, B. (2025). Biological Characteristics and Domestication of a Wild Hericium coralloides. Horticulturae, 11(8), 917. https://doi.org/10.3390/horticulturae11080917

